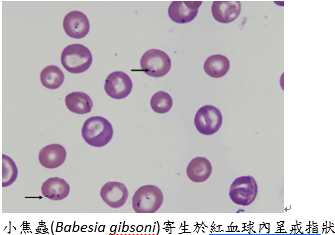

- 仁武總院
-
- 營業時間
- 週一、二、四、五、六、日 門診時段 09:30~02:00 週三 上午門診 09:30~12:30 午晚門診 16:30-02:00 急診時段,需加收急診費 21:00~02:00 ----止掛時間---- 週一、二、四、五、六、日 01:30 止掛 (需至現場報到) 週三 上午門診 12:00 止掛
- 院所地址
- 高雄市仁武區鳳仁路231號
- 聯絡電話
- (07)374-0964 #20
狗狗食慾不振、 尿液變色? 可能是焦蟲感染!
犬焦蟲感染症Canine Babesiosis
疾病介紹:
焦蟲感染症又稱壁蝨熱(tick fever)、德州熱(Texas fever)是一種由壁蝨媒介傳染的血液寄生蟲,當動物被壁蝨叮咬時焦蟲會藉由壁蝨唾液入侵宿主,在宿主紅血球內繁殖最後破壞血球釋放出更多蟲體,被感染的動物可能會終生帶原,動物康復後仍有復發的可能,焦蟲的種類多達100種以上,在台灣北部多以小焦蟲(Babesia gibsoni)較為常見。感染初期會有一些非特異性的症狀如發燒、食慾不振、精神下降、嘔吐、關節疼痛等,較嚴重者可能會有褐色尿液、黏膜蒼白、血小板減少、溶血性貧血、免疫抑制甚至危及生命。
診斷:
當有臨床症狀如發燒、食慾不振、精神下降、嘔吐、關節疼痛等會使用全血細胞計數(CBC)與血液抹片檢驗其紅血球白血球,如有貧血或是溶血的跡象時可使用焦蟲快篩試劑檢驗,快篩如呈陽性則需要做聚合酶連鎖反應(PCR)。一般快篩試劑如呈陽性只能代表病患感染過焦蟲,當下感染與否則以PCR為準。北部以小焦蟲Babesia gibsoni為主,南部以Babesia canis為主。
區別診斷:
1.艾利希體(Ehrlichia)
2.萊姆病(Lyme disease)
3.自體免疫性溶血(AIHA)
4.中毒(誤食可可鹼、洋蔥、老鼠藥)

治療:
以口服藥及針劑治療後檢驗血液內紅血球再生狀況,口服藥療程結束後需要以pcr和血液抹片確認體內蟲體數量,如貧血狀況嚴重則需要緊急輸血。
預防:
壁蝨叮咬後24~48小時感染焦蟲的機率較高,故定期使用口服或是滴劑驅蟲藥(如全能狗S、蚤不到、寵愛、一錠除等)成為預防焦蟲最直接的辦法,在外散步時也可以避開較高的草叢以減少被壁蝨叮咬的機率。發現愛犬被壁蝨叮咬時可以使用酒精對準壁蝨噴灑使其口器鬆開,接著再用鑷子或指尖夾緊壁蝨口器將其拔除。最後就算焦蟲治療已經完成也不能忘記預防壁蝨免得再次感染。
參考資料
- Ping-Jun Chung (2018) A PCR assay for simultaneous detection and differentiation of two common Babesia spp. Infecting dogs in Taiwan
- Fu- Siang Yang(2010) Molecular Epidemiology of Ehrlichiosis and Babesiosis of Stray Dogs in Northern Taiwan
文章來自:聯盟林口分院 蔡介文 醫師 2025.4.15
- 蔡介文
- 林口文化分院 獸醫師
-
經歷
- 亞洲大學學士後獸醫系學士
- 芝山動物醫院住院醫師
- 尼古拉動物醫院獸醫師
-
專長
- 一般犬貓內科
-
- 更多醫生資訊請至 聯盟動物醫院醫療團隊
- 旗楠分院
-
- 營業時間
- 2025/06/01起營業時間更正 週一、二、三、四、五、六、日 上午診 9:30-12:30 午晚診 14:30-21:30 ----止掛時間---- 上午診 12:00 止掛 午晚診 21:00 止掛
- 院所地址
- 高雄市楠梓區旗楠路106號
- 聯絡電話
- (07)353-5918 #20
- 鳳屏分院
-
- 營業時間
- 週一 11:00-13:00;15:00-21:00 週二 休診 週三 11:00-13:00;16:30-21:00 週四 11:00-13:00;15:00-21:00 週五 休診 週六 11:00-13:00;15:00-21:00 週日 11:00-13:00;15:00-21:00 (休診、閉院前半小時止掛)
- 院所地址
- 高雄市大寮區鳳屏一路35號
- 聯絡電話
- (07)702-1192 #20
- 建國分院
-
- 營業時間
- 2025/06/01起營業時間調整 週一、二、四、五、六、日 上午診 9:30-12:30 午晚診 14:30-21:30 週三 上午診 9:30-12:30 午晚診 16:30-21:30 ----止掛時間---- 上午診 12:00 止掛 午晚診 21:00 止掛
- 院所地址
- 802高雄市苓雅區建國一路195號
- 聯絡電話
- (07)2252557 #0720
- 岡燕分院
-
- 營業時間
- 2025/06/01起營業時間調整 週一、二、四、五、六、日 上午診 9:30-12:30 午晚診 14:30-21:30 週三休診 ----止掛時間---- 上午診 12:00 止掛 午晚診 21:00 止掛
- 院所地址
- 高雄市岡山區岡燕路608-1號
- 聯絡電話
- (07)625-7995 #0520
- 鳳山保華分院
-
- 營業時間
- 週二全天休診 週一、週三到週日 營業時間為中午 12:00 ~ 晚上 21:00 (下午 16:00 ~ 17:00 休診;週三為13:00 ~ 17:00 休診)
- 院所地址
- 高雄市鳳山區保華一路252號
- 聯絡電話
- (07)7965825#0920
- 林口文化分院
-
- 營業時間
- 營業時間:週一至週日 上午診 10:00-13:00 午晚診 15:00-21:00 ----止掛時間---- 上午診 12:30 止掛 午晚診 20:30 止掛
- 院所地址
- 新北市林口區文化二路二段68號2樓
- 聯絡電話
- (02)7755-2055 #0820
- 桃園龜山萬壽院
-
- 營業時間
- 營業時間:週一至週日 上午診 10:00-13:00 午晚診 15:00-21:00 ----止掛時間---- 上午診 12:30 止掛 午晚診 20:30 止掛
- 院所地址
- 桃園市龜山區萬壽路二段1125號
- 聯絡電話
- 03-3505565
- 屏東潮州志成院
-
- 營業時間
- 自10/6起,週一至週五暫停門診服務 週六、週日正常看診,營業時間為中午 12:00 ~ 晚上 21:00 (下午 16:00 ~ 17:00 休診) 休診前半小時止掛
- 院所地址
- 屏東縣潮州鎮志成路218號
- 聯絡電話
- 08-7885525



